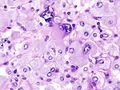

ورم القواتم
| Pheochromocytoma | |
|---|---|
| الأسماء الأخرى | Phaeochromocytoma, adrenal medullary tumor, Chromaffin Cell Tumors, Paraganglioma |
 | |
| Normal remnant adrenal gland (left) with a pheochromocytoma (right) involving the adrenal medulla | |
| النطق |
|
| التخصص | Endocrinology, oncology |
| الأعراض | Hypertension, tachycardia, sweating, صداع و pallor |
| المضاعفات | Hypertensive crisis |
| الطريقة التشخيصية | Elevated plasma free metanephrines, plasma catecholamines, or urinary catecholamines |
| العلاج | Surgery, chemotherapy, radiation, and pharmacologic agents |
| التردد | 0.8 per 100,000 person-years [2] |
ورم القواتم pheochromocytoma، هو أحد أورام الغدد الصم العصبية ينشأ من نخاع الغدد الكظرية (في الخلايا أليفة الكروم)، أو من الأنسجة أليفة الكروم خارج الغدة الكظرية. يفرز الورم كميات عالية من الكاتيكولامينات،[3] معظمهم من النورأدرينالين وبشكل أقل الأدرينالين. تعد الأورام المجاورة للعقدة العصبية الخارجة عن الغدة الكظرية (توصف بأنها ورم القواتم خارج الغدة الكظرية) أقل شيوعًا[4]، ومرتبطة ارتباطًا وثيقًا بالأورام التي تنشأ في عُقَد الجهاز العصبي الودي (السمبثاوي) وتُسمّى على أساس الموقع التشريحي.
تعد أورام القواتم نادرة، وهي أورام غير سرطانية عادةً (حميدة) تتطور في الغدة الكظرية. عادةً، هذا النوع من الورم يؤثر في واحدة من الغدتين الكظريتين، ولكن يمكن أن يؤثر في كلتيهما.
يُنتج الورم الهرمونات التي تتسبب إما في ارتفاع ضغط الدم المستمر أو العَرَضِي. في حال عدم العلاج، يمكن أن يتسبب ورم القواتم في أضرار جسيمة أو مهددة للحياة لأجهزة الجسم الأخرى، وخاصة جهاز القلب والأوعية.[5]
تتراوح أعمار معظم الأشخاص الذين يعانون ورم القواتم بين 20 و50، ولكن يمكن الإصابة بالورم في أي عمر. عادةً ما يعيد العلاج الجراحي لإزالة ورم القواتم ضغط الدم إلى مستواه الطبيعي.
العلامات والأعراض
 صورة مِجهرية عالية التكبير لورم القواتم بصبغة الهيماتوكسيلين والإيوسين. |
علامات وأعراض ورم القواتم هي أعراض فرط نشاط الجهاز العصبي الودي، [6] ومنها:
- ارتفاع معدل ضربات القلب
- نوبات ارتفاع ضغط الدم، (متقطعة)، مما يجعل من الصعب الكشف عن وجود ورم القواتم. ويحدث أيضًا انخفاض ضغط الدم الانتصابي (أي انخفاض ضغط الدم الانقباضي أكثر من 20 ملم زئبقي أو انخفاض ضغط الدم الانبساطي أكثر من 10 مم زئبق عند الوقوف)
- الخفقان
- القلق، غالبًا نوبات ذعر
- تعرق غزير
- الصداع - وهو العَرَض الأكثر شيوعًا
- شحوب
- ألم الخاصرة
- فقدان الوزن
- ترسُّبات من الأميلويد تُرى مِجهريًا
- ارتفاع مستوى السكر في الدم (ويرجع ذلك إلى تحفيز الكاتيكولامين لتحلل الدهون مما يؤدي إلى مستويات عالية من الأحماض الدهنية الحرة فتُثبّط امتصاص الجلوكوز بواسطة خلايا العضلات. وعلاوة على ذلك، تحفيز مستقبلات بيتا الأدرينالية يؤدي إلى تحلل الغليكوجين واستحداث السكر وبالتالي ارتفاع مستويات السكر في الدم).
ويُمكن أيضًا أن يسبب ورم القواتم ارتفاع ضغط الدم الشرياني المُقاوِم للعلاج. يمكن أن يكون ورم القواتم قاتلًا إذا كان يسبب ارتفاع شديد في ضغط الدم والذي يُضعف أجهزة الجسم (كان يُسمّى سابقًا "ارتفاع ضغط الدم الخبيث")..
لا تظهر العلامات والأعراض المذكورة مع كل المرضى. فالعَرَض الأكثر شيوعًا هو الصداع، والتعرُّق، وزيادة معدل ضربات القلب، مع اختفاء الأعراض في أقل من ساعة واحدة. قد ينمو الورم ويُصبح كبيرًا، ولكن معظمها أصغر من 10 سم (4 بوصات).
الأسباب
لا يعرف الباحثون ما يسبب أورام القواتم. يحدث الورم في خلايا معينة والتي تُسمَّى خلايا ألياف الكروم والتي توجد في وسط الغدة الكظرية. تطلق هذه الخلايا هرمونات معينة ويكون الأدرينالين أولها (الإپينفرين) والنورأدرينالين (النورإپينفرين)، والذي يساعد على التحكم في العديد من وظائف الجسم، مثل معدل ضربات القلب وضغط الدم والسكر في الدم.
قد يكون ما يصل إلى 25٪ من ورم القواتم عائليًا. الطفرات في الجينات VHL، RET، NF1 (جين 17 الورم العصبي الليفي من النوع 1)، كلها معروفة بتسببها في ورم القواتم العائلي، وبالتالي قد يكون المرض مصحوبًا بمرض فون هيبل لينداو، الورم العصبي الليفي، [7] أو ورم جنيب العقدة العصبية العائلي اعتمادًا على الطفرة.
ورم القواتم هو ورم من متلازمة تعدد أورام الغدد الصماء، نوع IIA و IIB (المعروف أيضا باسم MEN IIA و MEN IIB، على التوالي). وتشمل الأورام الأخرى المُكوّنة للمتلازمة: أورام الغدد جارات الدرقية، وسرطان الغدة الدرقية النخاعي، والطفرات الشائعة في الجين الوَرَمي RET.[8]
دور الهرمونات
يُعد الأدرينالين والنورأدرينالين هرمونين يحفزان مقاومة الجسم في حالة المحاربة أو الهروب تجاه الاستجابة للتهديدات. يقوم الهرمونان بتعزيز ارتفاع ضغط الدم وسرعة معدل ضربات القلب وتعزيز أجهزة الجسم الأخرى لتمكين رد الفعل السريع. تؤدي أورام القواتم إلى الإطلاق الشاذ والمفرط لهذين الهرمونين.
مسببات النوبات المصحوبة بأعراض
قد تحدث نوبات تلقائيًا أو قد تنجم عن عوامل مثل:
- الإجهاد البدني
- القلق والإجهاد
- التغييرات في وضع الجسم
- المخاض والولادة
- الجراحة والتخدير
النظام الغذائي
الأطعمة الغنية بالتيرامين، وهي مادة تؤثر على ضغط الدم، كما يمكن أن تؤدي إلى نوبة. يشيع التيرامين في الأطعمة المخمرة، أو القديمة، أو المخللة، أو شديدة النضج أو الفاسدة. تشمل هذه الأطعمة ما يلي:
- بعض أنواع الجبن
- بعض أنواع البيرة والنبيذ
- الشوكولاتة
- اللحوم المجففة أو المدخنة
الأدوية
تشمل بعض الأدوية التي يمكن أن تؤدي إلى نوبات مصحوبة بأعراض:
- مثبطات أكسيداز أحادي الأمين (MAOIs)، مثل الفنلزين Phenelzine (نارديل)، وترانيلسيپرومين Tranylcypromine (بارنات) وإيزوكاربوكسازيد Isocarboxazid (ماربلان)، والمنبهات، مثل الأمفيتامينات أو الكوكايين.
التشخيص


يمكن أن يتم التشخيص عن طريق قياس الكاتيكولامينات في البلازما (الدم) أو من خلال جمع البول على مدار 24 ساعة. يجب توخي الحذر لاستبعاد الأسباب الأخرى لزيادة الأدرينالين مثل نقص السكر في الدم، التوتر، المجهود، والأدوية التي تؤثر على الكاتيكولامينات مثل المنشطات، ميثيل دوبا، منبهات الدوبامين، أو خافضات ضغط الدم. كما يمكن أن تؤثر المواد الغذائية المختلفة (مثل القهوة والشاي والموز والشوكولاتة والكاكاو، والحمضيات، والفانيليا) على مستويات الميتانيفرين في البول وحمض الفانيليل مندليك[9].
يمكن أن يساعد التصوير المقطعي المُحَوْسب أو التصوير بالرنين المغناطيسي T2 على الرأس والرقبة، والصدر، والبطن في تحديد مكان الورم. ويمكن أيضًا تحديد المكان عن طريق المسح الضوئي MIBG، باستخدام metaiodobenzylguanidine . أما التحديد الأدق فيمكن الحصول عليه في بعض مراكز المسح باستخدام PET-CT أو PET-MRI مع 18F] fluorodopamine] أو FDOPA.[10]
ينبغي أن يعلم المرضى الذين يعانون من الأعراض المرتبطة بورم القواتم أنه أمر نادر الحدوث وغالبًا ما يمر دون تشخيص حتى تشريح الجثة. لذا يجب على المرضى توفير المعلومات الهامة للطبيب، مثل تسجيل ما إذا كان ضغط الدم يتغير بشكل ملحوظ خلال فترات القلق.[11]
الفحوصات
- اختبارات الدم: اقترح البعض أن تحليل (نورميتانيفرين وميتانيفرين) في بلازما الدم هو الاختبار الأكثر دقة للكشف عن ورم القواتم.
- اختبارات البول: على الرغم من أن هذا الاختبار أقل فعالية من اختبار البلازما إلا أنه لا يزال مهمًا للغاية في التشخيص. عادة ما تكون نواتج تكسير النورأدرينالين والأدرينالين، وهي: نورميتانيفرين (NMN) وميتانيفرين (MN)، موجودة بكميات صغيرة نسبيًا في الأشخاص الأصحاء. زيادة إفراز هذه المركبات يدل على المرض، ولكن لا يَستبعِد تمامًا غيره من الأمراض التي قد تسبب زيادة الإفراز أيضًا.
- اختبارات أخرى:
- أحد الاختبارات التشخيصية التي كانت تُستخدم من قبل لورم القواتم هو إعطاء الكلونيدين، وهو أحد العلاجات المُستخدَمة لحالات ارتفاع ضغط الدم. الكلونيدين يشبه الكاتيكولامينات في الدماغ، مما يؤدي إلى الحد من نشاط الأعصاب السمبثاوية المُسيطرة على نخاع الغدد الكظرية. يستجيب النخاع الكظري الصحي لاختبار الكلونيدين المُثبّط عن طريق الحد من إنتاج الكاتيكولامين. أما عدم حدوث استجابة فيدل على وجود ورم القواتم.
- يرتفع كروموغرانين (أ) في حالة ورم القواتم.[12]
موقع الورم
في البالغين: يصيب ما يقرب من 80٪ من ورم القواتم الغدة الكظرية على أحد الجانبين ويكون منفردًا، و 10٪ يصيب كلا الجانبين، و 10٪ منهم من خارج الغدة الكظرية. في الأطفال: ربع الأورام ثنائي، وربع من خارج الغدة الكظرية. الأورام المنفردة تكون أكثر على الجانب الأيمن لسبب غير معروف. وعلى الرغم من أن ورم القواتم قد ينمو إلى حجم كبير (> 3 كلغ)، إلا أن معظمها تزن <100 غرام وقُطرها <10 سم. يكون ورم القواتم غنيًا بالكثير من الأوعية الدموية.
تتكون الأورام من الخلايا أليفة الكروم والتي تكون كبيرة ومتعددة الأشكال. أقل من 10٪ من هذه الأورام خبيثة. وكما هو الحال مع العديد من أورام الغدد الصماء الأخرى، لا يمكن تحديد ماإذا كان الورم خبيثًا أم لا من المظهر النسيجي. يشير الانتشار للأنسجة المحيطة أو الانبثاث بعيدًا إلى كَوْن المرض خبيثًا.
ورم القواتم خارج الغدة الكظرية: تزن عادة بين 20 إلى 40 غرام وهي <5 سم في القطر. يقع معظمها داخل البطن، ارتباطًا بالعقد الهضمية، المساريقية العلوية، وأدنى العقد المساريقية وجهاز تسوكركاندل. ما يقرب من 10٪ في الصدر، 1٪ من داخل المثانة البولية، وأقل من 3٪ منهم في الرقبة، عادة مرتبطة مع العقد السمبثاوية أو فروع خارج القحف للعصب التاسع.
التشخيص التفريقي
يشمل التشخيص التفريقي لورم القواتم ما يلي:
- اضطرابات القلق، بما في ذلك متلازمة انسحاب البنزوديازيبين
- ورم جنيب العقدة العصبية
- مرض فون هيبل لينداو
- ارتفاع ضغط الدم
- فرط نشاط الغدة الدرقية
- ورم جزيري
- التسمم بالزئبق
- عدم انتظام دقات القلب فوق البطيني الانتيابي
- ارتفاع ضغط الدم وعائي كلوي
- ورم سرطاني[13]
العلاج
الخيار الأول للعلاج هو الاستئصال الجراحي للورم، إما عن طريق فتح البطن أو المنظار[14]. ونظرًا لتعقد الجراحة، واحتمال حصول مضاعفات أثناء وبعد الجراحة، لايجب أن يتم تنفيذ هذه الجراحة إلا في مراكز ذات خبرة في علاج هذا المرض. قد يكون من الضروري أيضًا استئصال الكظر، أي الاستئصال الجراحي الكامل للغدة الكظرية المتضررة. يتطلب الخيار الجراحي معالجة مُسبَقة بمانع مستقبلات ألفا الأدرينية مثل فينوكسيبنزامين أو مضادات ألفا قصيرة المفعول (مثل برازوسين، تيرازوسين، أو دوكسازوسين)[15]. القيام بذلك يسمح للجراحة المُضيّ قدمًا مع التقليل من احتمال ارتفاع ضغط الدم الشديد أثناء العملية. يوصي البعض باستخدام محصرات ألفا / بيتا مجتمِعة مثل لابيتالول من أجل إبطاء معدل ضربات القلب. يجب ألا تُستخدَم أبدًا حاصرات مستقبلات بيتا-1 الانتقائية مثل أتينولول في وجود ورم القواتم حيث يسبب ارتفاع ضغط الدم الشديد نتيجة عمل مستقبلات ألفا وحدها. ولكن بعض المبادئ التوجيهية السريرية تسمح باستخدام حاصرات بيتا 1 جنبًا إلى جنب مع حاصرات ألفا خلال الجراحة للسيطرة على عدم انتظام دقات القلب.
عادة ما ينخفض حجم الدم في مرضى ورم القواتم. بعبارة أخرى، فإن حالة ارتفاع الأدرينالين بشكل مُزمِن نتيجة ورم القواتم الغير مُعالَج تؤدي إلى تثبيط شبه كامل لنشاط الرينين أنجيوتنسين، فيزيد فقدان السوائل في البول وبالتالي انخفاض حجم الدم. ومن هنا، بمجرد استئصال ورم القواتم، (إزالة المصدر الرئيسي للكاتيكولامينات)، تنشأ حالة انخفاض النشاط ونقص حجم الدم. يمكن أن يؤدي هذا إلى انخفاض ضغط الدم الشديد. ولذلك، فإنه عادة ما يُنصح بزيادة الملح لمرضى ورم القواتم قبل الجراحة الخاصة بهم. عن طريق استهلاك الأغذية عالية الملح قبل الجراحة، أو من خلال محلول ملحي في الوريد.
المضاعفات
يمكن أن يسبب خروج كميات هائلة من الكاتيكولامينات في ورم القواتم تلف خلايا القلب. قد يكون هذا الضرر إما بسبب تدهور الشرايين التاجية أو نتيجة للتأثيرات السُمّية مباشرة على خلايا القلب.
عوامل الخطر
إن الأشخاص المصابين باضطرابات موروثة نادرة أكثر عرضة لورم خلايا الكروماتين القاتمة أو ورم المستقتمات، ومن المحتمل أن تكون الأورام المصاحبة لهذه الاضطرابات سرطانية. وتتضمن هذه الحالات المرضية الوراثية ما يلي:
- الورم الصماوي المتعدد Multiple endocrine neoplasia من النوع الثاني (MEN II) هو اضطراب ينشأ عن ظهور أورام في أكثر من جزء من جهاز (الغدد الصماء) الذي يفرز الهرمونات داخل الجسم. يمكن أن تظهر أورام أخرى مرتبطة بالورم الصماوي المتعدد من النوع الثاني على الغدة الدرقية والجار درقية والشفاه واللسان والقناة المعدية المعوية.
- مرض فون هيپل-لينداو Von Hippel–Lindau disease يمكن أن يتسبب في حدوث أورام في مناطق متعددة، وتشمل الجهاز العصبي المركزي وجهاز الغدد الصماء والبنكرياس والكلى.
- الورم الليفي العصبي neurofibroma النمط 1 (NF1) يتسبب في أورام متعددة في الجلد (الأورام العصبية الليفية) وبقع الجلد الصبغية وأورام العصب البصري.
- متلازمات ورم المستقتمات الوراثية هي اضطرابات موروثة تؤدي إما إلى أورام خلايا الكروماتين القاتمة أو أورام المستقتمات.
الأورام السرطانية
في أحيان نادرة، يكون ورم القواتم سرطانيًا (خبيثًا)، وتنتشر الخلايا السرطانية إلى أجزاء أخرى من الجسم (تنتقل). غالبًا ما تنتقل الخلايا السرطانية من ورم القواتم أو ورم المستقتمات إلى الجهاز الليمفاوي، أو العظام، أو الكبد، أو الرئتين.
علم الأوبئة
يحدث ورم القواتم في 2-8 أشخاص من كل مليون نسمة، مع ما يقرب من 1000 حالة يتم تشخيصها في الولايات المتحدة سنويًا. يصيب في الغالب الشباب أو منتصف العمر في البالغين، أو يحدث مُبكرًا في الحالات الوراثية. يُطلَق عليه ورم الـ10٪.
- حوالي 10٪ من الحالات الكظرية ثنائية تصيب كلا الجانبين (مما يشير إلى مرض وراثي)
- حوالي 10٪ من الحالات الكظرية تحدث في الأطفال (يشير أيضًا إلى مرض وراثي)
- حوالي 15٪ من خارج الغدة الكظرية، ومن بين هؤلاء 9٪ في البطن، وتقع 1٪ في أماكن أخرى. بعض ورم القواتم خارج الغدة الكظرية هي في الواقع ورم جنيب العقدة العصبية، ولكن لا يمكن معرفة الفارق إلا بعد الاستئصال الجراحي.
- نحو 11.1٪ من الحالات الكظرية خبيثة، وترتفع إلى 30٪ في الحالات خارج الغدة الكظرية
- حوالي 15-20٪ حالات وراثية[16]
- حوالي 5٪ نتيجة مرض فون هيبل لينداو
- حوالي 3٪ من الحالات تنتكس بعد الاستئصال
أوراق ذات صلة
بالرغم من وجود معظم خلايا ألياف الكروم في الغدد الكظرية، توجد مجموعات صغيرة من هذه الخلايا أيضًا في القلب والرأس والعنق والمثانة والجدار الخلفي للبطن وبطول العمود الفقري. تسمَّى الأورام التي تصيب ألياف الكروم أورام المستقتمات Paragangliona والتي يمكن أن تؤدي إلى النتيجة ذاتها على الجسم.
التاريخ
في عام 1886، قدَّم فيليكس فرانكل أول وصف لمريض مُصاب بورم القواتم. كان أول من صاغ مصطلح "ورم القواتم" هو الطبيب الشرعي لودڤيگ پيك، في عام 1912. وفي عام 1926، كان سيزار رو (في سويسرا) وتشارلز هوراس مايو (في الولايات المتحدة الأمريكية) أول جراحين لإزالة ورم القواتم بنجاح.
في سبعينات القرن العشرين، استخلص كل من غرين وتشلر خطًا من الخلايا، سُمّي بخط الخلية PC12، من ورم القواتم في الفئران.[17]
انظر أيضاً
الهامش
- ^ https://www.lexico.com/definition/phaeochromocytoma
- ^ Beard CM, Sheps SG, Kurland LT, Carney JA, Lie JT (December 1983). "Occurrence of pheochromocytoma in Rochester, Minnesota, 1950 through 1979". Mayo Clinic Proceedings. 58 (12): 802–4. PMID 6645626.
- ^ Boulpaep, Emile L.; Boron, Walter F. (2003). Medical physiology: a cellular and molecular approach. Philadelphia: Saunders. p. 1065.
{{cite book}}: Cite has empty unknown parameters:|lay-date=,|subscription=,|nopp=,|last-author-amp=,|name-list-format=,|lay-source=,|registration=, and|lay-summary=(help) - ^
{{cite web}}: Empty citation (help) - ^ ورم القواتم، مايو كلينيك
- ^ Pheochromocytoma: Symptoms, Treatment, Diagnosis, Test Archived 2017-07-16 at the Wayback Machine
- ^ Goldman 2011, pp. 1194
- ^ Mendelian Inheritance in Man (OMIM) 171400
- ^
{{cite web}}: Empty citation (help) - ^ 6-L-18F-fluorodihydroxyphenylalanine PET in neuroendocrine tumors: basic aspects and emerging clinical applications, Journal of Nuclear Medicine 2008, 49, 573-586. DOI: 10.2967/jnumed.107.045708
- ^ Goldman 2011, pp. 185
- ^ Tumori. 91 (1). PMID 15850005.
{{cite journal}}: Invalid|display-authors=8(help); Missing or empty|title=(help); Unknown parameter|الأخير1=ignored (help); Unknown parameter|الأخير2=ignored (help); Unknown parameter|الأخير3=ignored (help); Unknown parameter|الأخير4=ignored (help); Unknown parameter|الأخير5=ignored (help); Unknown parameter|الأول1=ignored (help); Unknown parameter|الأول2=ignored (help); Unknown parameter|الأول3=ignored (help); Unknown parameter|الأول4=ignored (help); Unknown parameter|الأول5=ignored (help); Unknown parameter|السنة=ignored (help); Unknown parameter|الصفحات=ignored (help); Unknown parameter|العنوان=ignored (help) - ^ Giannini, A. James; Black, Henry R.; Goettsche, Roger L. (1978). Psychiatric, Psychogenic and Somatopsychic Disorders Handbook. Garden City, NY: Medical Examination. pp. 213–4.
{{cite book}}: Cite has empty unknown parameters:|lay-date=,|subscription=,|nopp=,|last-author-amp=,|name-list-format=,|lay-source=,|registration=, and|lay-summary=(help) - ^ Mayo Clinic Proceedings. 78 (12). doi:10.4065/78.12.1501. PMID 14661679.
{{cite journal}}: Missing or empty|title=(help); Unknown parameter|الأخير1=ignored (help); Unknown parameter|الأخير2=ignored (help); Unknown parameter|الأخير3=ignored (help); Unknown parameter|الأخير4=ignored (help); Unknown parameter|الأخير5=ignored (help); Unknown parameter|الأول1=ignored (help); Unknown parameter|الأول2=ignored (help); Unknown parameter|الأول3=ignored (help); Unknown parameter|الأول4=ignored (help); Unknown parameter|الأول5=ignored (help); Unknown parameter|السنة=ignored (help); Unknown parameter|الصفحات=ignored (help); Unknown parameter|العنوان=ignored (help) - ^ J Clin Endocrinol Metab. 92 (11). doi:10.1210/jc.2007-1720. PMID 17989126.
{{cite journal}}: Missing or empty|title=(help); Unknown parameter|الأخير1=ignored (help); Unknown parameter|الأول1=ignored (help); Unknown parameter|السنة=ignored (help); Unknown parameter|الصفحات=ignored (help); Unknown parameter|العنوان=ignored (help) - ^ Goldman 2011, pp. 1470
- ^ Proc. Natl. Acad. Sci. U.S.A. 73 (7). Bibcode:1976PNAS...73.2424G. doi:10.1073/pnas.73.7.2424. PMC 430592. PMID 1065897 https://www.ncbi.nlm.nih.gov/pmc/articles/PMC430592.
{{cite journal}}: Cite has empty unknown parameter:|المسار=(help); Missing or empty|title=(help); Unknown parameter|الأخير2=ignored (help); Unknown parameter|السنة=ignored (help); Unknown parameter|الصفحات=ignored (help); Unknown parameter|العنوان=ignored (help); Unknown parameter|المؤلف=ignored (help)
وصلات خارجية
- Pheochromocytoma clinical trial currently recruiting patients
- Pheochromocytoma clinical trial currently recruiting patients
- GeneReviews/NIH/UW entry on Hereditary Paraganglioma-Pheochromocytoma Syndromes
- MedlinePlus Overview pheochromocytoma
- overview from National Cancer Institute
- Cancer.Net: Neuroendocrine Tumor